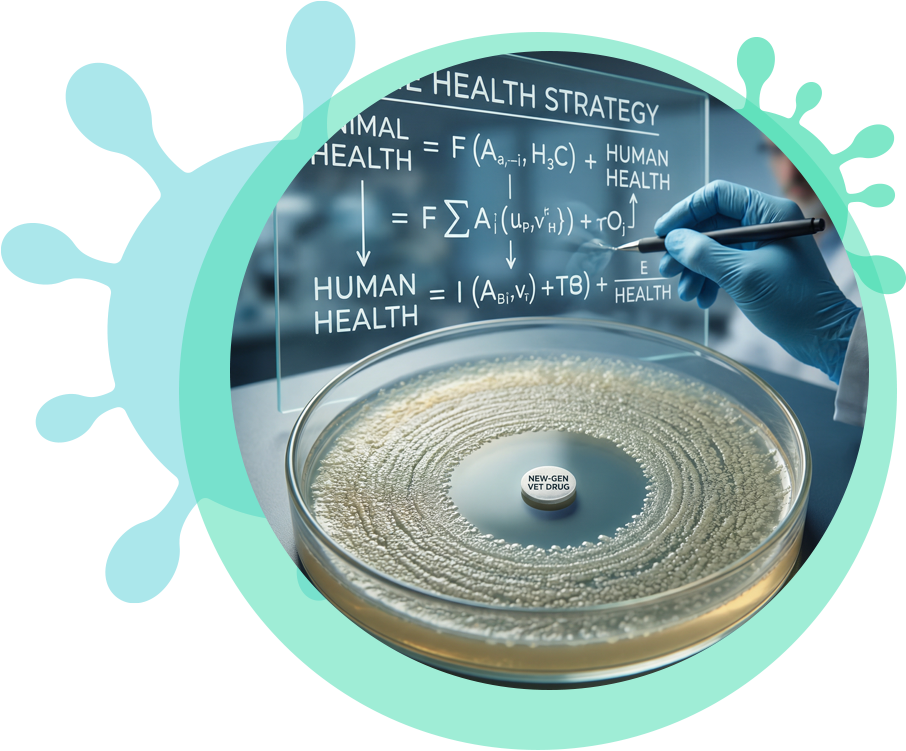

Nemzeti Laboratórium: Az úttörő
Ez a központosított erőforrás- és tudásmegosztás lehetővé teszi a gyors információcserét és az innovatív megoldások gyorsabb alkalmazását. Az együttműködésben számos szakterület képviselői dolgoznak együtt, többek között állatorvosok, humán orvosok, biológusok, mikrobiológusok, immunológusok, informatikusok és mérnökök. A Nemzeti Laboratórium munkájának középpontjában az AMR elleni küzdelem áll, ami a predikciók szerint 2050-re vezető halálokká válhat az emberek körében. A labor országos felméréseket végez több mint 40 baromfi- és sertéstelepen, ahol aggasztóan magas, 50–60% körüli fluorokinolon-rezisztenciát mutattak ki baromfiállományokban. Az AMR kockázatának megelőzésére a labor gépi tanulási algoritmusokat és SHAP-elemzést alkalmaz, összekapcsolva az antibiotikum-fogyasztási, termelési és környezeti tényezőkre (pl. hőmérséklet, csapadék) vonatkozó adatokat. Ezzel a komplex megközelítéssel előrejelzéseket készítenek, és proaktív döntéstámogatást (dashboardok) kínálnak a gazdálkodóknak. Az adatokat a GDPR-nak megfelelően anonimizálják a gazdálkodók biztonsága érdekében.


Ez a központosított erőforrás- és tudásmegosztás lehetővé teszi a gyors információcserét és az innovatív megoldások gyorsabb alkalmazását. Az együttműködésben számos szakterület képviselői dolgoznak együtt, többek között állatorvosok, humán orvosok, biológusok, mikrobiológusok, immunológusok, informatikusok és mérnökök.
A Nemzeti Laboratórium munkájának középpontjában az AMR elleni küzdelem áll, ami a predikciók szerint 2050-re vezető halálokká válhat az emberek körében. A labor országos felméréseket végez több mint 40 baromfi- és sertéstelepen, ahol aggasztóan magas, 50–60% körüli fluorokinolon-rezisztenciát mutattak ki baromfiállományokban. Az AMR kockázatának megelőzésére a labor gépi tanulási algoritmusokat és SHAP-elemzést alkalmaz, összekapcsolva az antibiotikum-fogyasztási, termelési és környezeti tényezőkre (pl. hőmérséklet, csapadék) vonatkozó adatokat. Ezzel a komplex megközelítéssel előrejelzéseket készítenek, és proaktív döntéstámogatást (dashboardok) kínálnak a gazdálkodóknak. Az adatokat a GDPR-nak megfelelően anonimizálják a gazdálkodók biztonsága érdekében.
A megelőzés területén a labor alternatív megoldásokat is fejleszt: kutatják a bakteriofágok (“baktériumevő” vírusok) alkalmazását, és folyamatosan bővítik fágbankjukat, melyben mára több mint 200 fágizolátum található, amelyeket többek között ESBL-termelő (kiterjedt spektrumú antibiotikum-lebontó enzimet termelő) Escherichia coli ellen is tesztelnek. Ezenkívül fejlesztik a fermentált takarmányok és probiotikumok technológiáját, amelyek ipari melléktermékek (DDGS, sajtsavó) újrahasznosításával járulnak hozzá a fenntarthatósághoz, és kevesebb antibiotikummal érnek el hatékonyabb védekezést az állatok bélrendszerében. A gyorsdiagnosztika terén áttörést értek el a Mycoplasma kimutatásában, a diagnosztikai időt a korábbi hetekről/hónapokról 1–2 napra csökkentve, ami lehetővé teszi a célzott antibiotikum-terápiát. A labor elért eredményei közé tartozik továbbá 5 szabadalom, valamint közel 100 világszínvonalú publikáció, és egy Mycoplasma hyorhinis elleni vakcinajelölt értékesítése egy multinacionális gyógyszercégnek. A kutyák fülgyulladásáért felelős baktériumtörzsek ellen is végeznek fágizolálásokat, továbbá kutyák részére fejlesztenek nanotechnológiás szemkenőcsöt is. A jövő kutatásainak alapjául szolgál a Nemzeti Laboratórium kórokozóbankja is, amely földrajzilag lefedett, hazai baktériumtörzseket tárol, melyeket a MALDI-TOF tömegspektrométer segítségével percek alatt azonosítanak. A laboratóriumi munka hosszú távon a járványok megelőzését és a zoonózisok (állatokról emberre terjedni tudó betegségek) terjedésének csökkentését célozza, ezzel hozzájárulva a fenntartható állattenyésztéshez és a magyar biotechnológiai ipar versenyképességének növeléséhez.